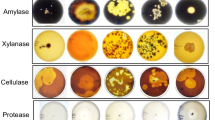

Abstract
Microbiological control programmes at industrial level should aim at reducing both the detrimental effects of microorganisms on the process and the environmental impact associated to the use of biocides as microbiological control products. To achieve this target, new efficient and environmentally friendly products are required. In this paper, 17 non-specific, commercial enzymatic mixtures were tested to assess their efficacy for biofilm prevention and control at laboratory and pilot plant scale. Pectin methylesterase, an enzyme found in the formulation of two of the mixtures tested, was identified as an active compound able to reduce biofilm formation by 71% compared to control tests.
Similar content being viewed by others
Avoid common mistakes on your manuscript.
Introduction
The formation of biofilms can cause industrial, environmental and health problems often resulting in operation failure and in a loss of product quality. Process waters in paper mills present high nutrient concentrations and temperatures from of 25°C to 45°C, being therefore an appropriate medium for high microbial growth. In the production of recycled paper, most of the microorganisms are introduced in the system with the raw materials although additives and water may be also contaminated. In the process, water microbes find ideal living conditions, which inevitably lead to massive microbial growth. Volatile compounds produced by microbes (e.g., organic acids, sulphur compounds and amine compounds) and the development of biofilms can cause bad odours and/or unacceptable quality defects. Moreover, these problems are worsened by the increased use of recovered paper and by the closure of the water circuits, both leading to higher organic loads and higher circuit water temperatures (Blanco et al. 1996; Blanco 2003; Lahtinen et al. 2006; Rättö et al. 2006).
In general terms, a biofilm can be conceived as a structured community of bacteria enclosed in a self-produced polymeric matrix and adhered on an inert or living surface (Costerton 2007; Van Houdt and Michielis 2005). Established biofilms can tolerate antimicrobial agents at concentrations of 10–100 times higher than those needed to kill genetically equivalent planktonic bacteria, making them extremely difficult to eradicate (Bardouniotis et al. 2003; Burmolle et al. 2006; Jefferson 2004).
Paper manufacturers have traditionally used biocides such as chlorine, bromine, isothiazolones, glutaraldehyde and others at different points of the process for various purposes; for example, to preserve raw materials and filler slurries, to prevent the formation of biofilm deposits and bad odours or to avoid the corrosion of machine components (Torres et al. 2008). Some microorganisms, however, can develop resistance to these biocides, which justifies the development of new microbiological control aids. In addition, biocides are not always able to penetrate biofilms and to remove them from the surfaces. Furthermore, most of biocides traditionally employed are hazardous substances, whose use is regulated by legal requirements (Directive 98/8/EC 1998; REACH 2006), being a potential source of pollution problems in effluents and in the environment (Blanco et al. 1996; Blanco 2003; Johnsrud 1997; Schenker and Gould 1996; Van Haute 1999; Bott 1998).
Current strategies to prevent biofouling should be environmentally friendly and should impede the contact between organisms and surfaces and/or prevent colonising organisms from building up to problematic levels. One of those strategies is based in the use of dispersants.
Dispersants may be applied in process waters as a single agent to prevent the formation of biofilm, or they may be complemented with biocide treatments of microbiologically sensitive raw materials (Johnsrud 1997; Schenker and Gould 1996). Dispersants do not always kill or inhibit the growth of microorganisms, although some present selective inhibition of biofilm-forming bacteria (Johnsrud 1997). Because of this, neither the determination of their optimal dosage nor the evaluation of their effect should be based only on cell counts. Dispersants may affect paper chemistry by decreasing resistance to water penetration, increasing moisture retention, or by favouring foaming. Dispersant-based biofilm control systems can also attack other non-biofilm deposits and, therefore, their effects on the whole papermaking process should be considered when they are to be applied.
Another alternative to biocides is the use of enzymatic treatments. Enzymes may affect colonisation and adhesion of microorganisms in four different ways. Firstly, they may attack the adhesive of settling organisms, thus preventing the settlement event (Longhi et al. 2008; Oulahal et al. 2007). Secondly, enzymes may degrade the polymers in the biofilm matrix formed by proliferating, settled organisms. Thirdly, enzymes may catalyse the release of antifouling compounds from the surface. These compounds may be non-toxic or toxic, but they can be much less stable than conventional biocides, what should prevent the problem of bioaccumulation of harmful chemicals. Finally, the intercellular communication during colonisation of a surface may be hindered by specific enzymes (Kristensen et al. 2008).
There are two main approaches to develop effective enzymatic products for paper industry application: (1) identifying the polysaccharides present in the biofilm and looking for specific enzymes able to degrade those (Verhoef et al. 2005) and (2) identifying active compounds in different enzymatic products and assessing their effects on biofilm. In this latter approach, the specificity in the enzymes mode action makes it a complex technique, increasing the difficulty of identifying enzymes that are effective against all the different types of biofilms. Therefore, formulations containing several different enzymes seem to be fundamental for a successful biofilm control strategy (Simoes et al. 2010). This second alternative has not yet been considered in published studies, and there are only a few works about the effects of specifically designed enzymes on biofilms in papermaking. These have been carried out with a levan hydrolase and a family of products called Darazyme, developed by Grace Dearborn's group and were based in the preliminary identification of biofilm components and the subsequent application of an enzyme or a combination of enzymes specifically selected to degrade the identified polysaccharides (Bajpai 1999).
This paper focuses on the second approach and presents a comparative study of the biofilm-preventing and degrading ability of 17 commercial non-specific enzymatic products on the biofilm formed by isolated bacteria from paper mills.
Materials and methods
Enzymes
Seventeen commercial enzymatic products not specifically developed for biofilm treatments (from Novozymes® A/S, Krogshoejvej 36, DK-2880 Bagsvaerd, Denmark) were evaluated to assess their effects on biofilm. Table 1 shows the main activities of the different products.
Continuous flow systems
The effect of enzymes on biofilm formation was studied using two continuous-flow bioreactors, whose volumes were 300 mL (B300 mL) and 10 L (B10 L). They were designed to allow biofilm growth on coupons, being a modification of the lab scale Pedersen device developed in 1982 (Pedersen 1982). The inflow of the chamber was connected by silicon tubes (B300 mL) or PVC tubes (B10 L) to a peristaltic pump and to a process water tank, and the outflow was recirculated to the tank (Fig. 1). Each flow chamber contained ten PVC coupons with spaces of 5 mm between them. The total volumes of liquid in the circuits were 300 mL and 10 L, respectively. The centrifugal pump was set up to move this volume of liquid with a flow of 0.29 L/s. Fresh process waters were pumped from the feeding tank to the stirred tank continuously (50 mL/day for B300 mL and 250 mL/day for B10 L). The total volume of process water was kept constant through the removal of exceeding process waters from the stirred tank. The flow through the coupon chambers was 0.10 L/s to assure turbulent flow. Since the hydrodynamic conditions affect notably the biofilm build-up, and it is very difficult to reproduce the hydrodynamic conditions of the mill at laboratory scale, the effect of the enzymes on biofilm build-up was studied at constant and turbulent hydrodynamic conditions, which allows comparing the results obtained and therefore, establishing the effect of each treatment on the biofilm build-up by comparing it with the control sample.
Experimental procedure
Preliminary laboratory trials in B300 mL
Before starting the experiment, the bioreactors were cleaned with detergent and ethanol and flushed with sterilised distilled water. The coupons were degreased and sterilised with acetone and ethanol and thereafter washed with sterilised distilled water and placed in the flow chamber.
The bioreactors were inoculated with the flora present in the process water obtained from the sheet-forming zone of the wire section of a 100% recycling paper mill, which uses mixed recovered paper as raw material and produces paper for board (Mill 1). The experiments were carried out at a controlled pH of 6.8–7.0 and at 30°C. Seventeen enzymatic compounds were studied. The dosage of the commercial enzyme preparations was 1,000 ppm for all the tests.
The experiments with B300 mL were carried out over 4 days, and the flow chamber was opened every 24 h to remove two coupons. One coupon was used to quantify biofilm formation, based on its dry weight (milligram per square centimetre) after 6 h at 105°C, and the other one was used to measure the colony forming units per square centimetre of coupon (CFU/cm2). For this latter measurement, coupons were removed with sterile forceps and flushed with 9 mL sterile physiological solution to remove slightly adhered cells and the excess of aqueous medium. Biofilms were swabbed from one side of each coupon with sterile cotton wool sticks and transferred to a vial containing a known volume of sterile physiological solution. This suspension was vortexed (20 s) to disperse cells, then, with each obtained sample, a series of dilutions was performed and plated on plate count agar. Plates were incubated at 30°C for 48 h. Then, the colony forming units per square centimetre was determined. The aqueous medium of the bioreactor was aseptically sampled at similar intervals and the number of colony forming units per millilitre (CFU/mL) was determined accordingly. The results of these preliminary trials allowed selecting three treatments for further studies in B10 L.
Laboratory trials in B10 L
The experiments were carried out over 4 days. Water samples and coupons were taken every 24 h, and biofilm formation on coupons was determined by counting and weighting, following the procedure explained before for the trials in B300 mL. Process waters from Mill 1 were used for the experiments. This water, rich in fibres, fines and filler was sampled from sheet-forming zone of the wire section and stored at 15°C. Before being used in B10 mL, process waters were sequentially filtered through 1 mm, 600, 400, 200 and 63 μm filters, which reproduce the disc filter treatment employed in the mill to obtain clarified waters.
The colonisation ratio (CR) was calculated from the ratio between the total number of CFU on the coupon (A) and the total number of CFU in contact with a coupon (C) as indicated by the Eq. (1). The latter (C) was defined as the sum of the total number of CFU in the medium (B) and the total number of CFU on the coupon (A), Eq. (2). A and B are defined by Eqs. (3) and (4), where CS is the coupon surface (square centimetre) and TVL is the total volume of liquid in the reactor (millilitre). In this way, comparison was possible between experiments with different starting conditions (Kielemoes et al. 2002).
Finally, only one commercial enzymatic product was selected for further tests. These were first carried out in the B10 L over 10 days. To ensure that the bacterial population was maintained at a constant level throughout the experiment, a count of microorganisms in the medium was carried out each 24 h observing that the bacterial concentration in process water was maintained between 106 and 107 CFU/mL. Biofilm build-up was assessed every 24 h, through the measurement of the dry weight of biofilm deposited on the coupons.
Pilot circuit trials
To identify the active compound having the predominant role against biofilm, two commercial products, containing fractions of the most active product selected from the 17 commercial products were also studied. This set of experiments was carried out in a pilot circuit simulating the process water circuit in a paper mill that considers fresh water addition and the removal of exceeding waters.
The pilot circuit consisted of two bioreactors BioFlo3000®, manufactured by New Brunswick Scientific (USA), one used to test the effect of the treatments, and the other used as control, allowing bacterial growth under a controlled environment: temperature (45°C), pH (7), dissolved oxygen (up to 20%) and turbulent regime (Reynolds number > 2,000). High density polypropylene coupons were immersed in each bioreactor to allow the formation of deposits.
Process waters from a 100% recycled paper mill producing writing and printing papers were used for the experiments (Mill 2). Again, this water was sampled from the sheet-forming zone of the wire section and stored at 15°C. Before being used in the pilot circuit, process waters were successively filtered by following the same procedure as explained for trials in B10 L.
All experiments were carried out by duplicate. To test the ability of the enzymatic treatment to prevent the biofilm formation, enzyme was continuously added during 10 days from the beginning until the end of the experiment to keep a constant concentration of enzyme of 1,000 ppm. Each day, the total colony number of aerobic bacteria in the waters was assessed by the dry-rehydratable film method (Petrifilm3M™). Counting results are expressed as the number of colony forming units (CFU/mL). At the end of the experiment, the total amount of dry weight of biofilm formed on the coupons was measured.
To exclude the effect of non-enzyme components in the commercial product, a test with denatured enzyme was carried out with process water from Mill 2 with a clean circuit. Enzyme inactivation was achieved by heat (121°C, 30 min.). The inactive enzyme was added continuously during the test to keep constant a concentration 1,000 ppm, and the effects were compared to the biofilm production in a control experiment without enzyme.
Experiments with different doses of the best product were also performed in clean circuits. The best treatment was applied continuously in three bioreactors fed with process waters form Mill 2. Three different concentrations were tested: 100, 10 and 1 ppm. A fourth bioreactor without treatment was used as control.
Results
Preliminary laboratory trials
The qualitative effectiveness of the treatments for preventing the formation of biofilm is presented in Table 1. From the group of the 17 treatments assessed, Pectinex Smash® was the most effective in preventing the adhesion of viable colony forming units on the coupons and the biofilm formation. Viscozyme L®, Pulpzyme ®, Terminox ® and Bio-feed Beta L® showed a moderate effect. The treatment with Novozyme 863® had no hindering effect on the formation of biofilm, although a significant low number of CFU was measured on the coupon when this product was tested, which was unexpected. Therefore, Novozymes 863 ®, Pectinex Smash® and Viscozyme L® were chosen for further investigations.
Laboratory trials with B10 L
The results obtained from the test of the selected enzymatic products with B10 L are shown in Fig. 2. The graphs show the number of colony forming units (CFU/mL) in the medium, the number of viable counts per surface unit of the coupon (CFU/cm2), the dry weight biofilm on the of coupon and the colonisation ratio. Biofilm formation was evaluated by an increased dry weight of the biofilm deposited on the coupon and by the colonisation ratio. The dry weight increase is caused by bacterial colonisation and through the production of exopolysaccharides (EPS). An increasing colonisation ratio indicates the formation of biofilm.
The addition of the tested enzymes did not change the value of the colony forming units per millilitre in the medium over the time, which remained constant in all cases and similar to the value measured in the control sample. This indicates that the tested enzymatic preparations did not have an undesired biocide effect.
When no treatment was added (control trial), both, the number of CFU on the coupon and the dry weight of material on the coupon increased, whereas the number of CFU in the medium stayed mainly constant, which indicates that bacteria were actively colonising the surface and producing biofilm. In fact, the biofilm was already formed after 24 h and increased during the course of the experiment. The colonisation ratio increased rapidly after 48 h and approached the value of 100% after 96 h, which implies that nearly all bacteria present in the coupon biofilm were viable.
When an enzymatic treatment was used, the number of viable colony forming units per square centimetre of coupon increased during the first 24 h to reach a value higher than that obtained for the control sample. This unexpected effect is in accordance with the observations made by other authors that have proved that the presence of salts, disinfectants or some other compounds, or other bacteria can increase the adhesion of bacteria and even the biofilm maturation (Carpentier and Chassaing 2004; Jensen et al. 2007). However, after the initial increase, the value of colony forming units per square centimetre remained constant (see the results for Novozyme 863® and Pectinex Smash® in Fig. 2) or even decreased slightly after 72 h (in the case of Viscozyme L®). As a result, the colonisation ratio was kept below 20% during the trials with enzymes, and the final number of bacteria colonising or growing on the surface was lower than that for the control trial. The effect of Novozyme 863® and Viscozyme L® on the dry weight of biofilm deposited on the coupons was significantly weaker from that of the Pectinex Smash® trial.
The addition of Novozyme 863® or Viscozyme L® did not prevent the build-up of organic material on the coupon, although they limited it and the final values were less than half the value reached at the end of the control trial. However, the addition of Pectinex Smash® prevented the build-up of organic material on the coupon weight maintaining it below 0.2 g. Furthermore, the colonisation ratio was kept low during the whole trial, which implies that the treatment reduced the biofilm on the coupon surface both by limiting the number of bacteria colonising the surface and by reducing the formation of biomass on the coupon. Therefore, Pectinex Smash® treatment was chosen to continue the study with pilot circuit trials.
Pilot circuit trials
During the pilot circuit trials, the bacterial concentration in the water remained between 2.3 × 106 and 7 × 107 in all the cases. When no treatment was applied, the biofilm formed after 72 h of trial was evident by visual observation of the coupons surface. The dry weight of the biofilm deposited on the coupons in the bioreactor with addition of Pectinex Smash® was between 4 and 5 times lower than that in the bioreactor without enzymatic treatment (Fig. 3). Therefore, the addition of Pectinex Smash® in a clean circuit limited dramatically the production of biofilm on the polypropylene coupons placed in the bioreactor under turbulent conditions.
Test with denatured Pectinex Smash®
During the experiments with the inactivate Pectinex Smash® solution, the total bacterial count in the waters did not vary significantly (107–108 CFU/mL). No significant differences were observed between the dry weight of biofilm deposited on the coupons in the bioreactor with inactive Pectinex Smash® and that in the bioreactor without any treatment (all the measured dry weights obtained on the coupons after 260 h were in the interval 1.4 ± 0.3 mg/cm2). These results suggest that the biofilm prevention properties of the Pectinex Smash® solution were not due to non-enzymatic components.
Effect of Pectinex Smash® dosification
During the test performed during 190 h, no significant variation in the total bacterial count was observed in the four bioreactors. After 24 h, biofilm formation was evident by visual observation of the coupons in the bioreactor without treatment and in that with Pectinex Smash® treatment at 1 ppm. In the bioreactor with 10 and 100 ppm of enzyme, biofilm on the coupons was visually detected only after 48 h. The dry weight of slime on the coupons from the bioreactor without treatment or with 1 ppm of Pectinex Smash® was very similar, which indicates that a concentration of 1 ppm of Pectinex Smash®, did not affect biofilm production (Fig. 4). A moderate effect against biofilm build-up was observed with the treatment at 10 ppm concentration, which decreased the weight of slime on the coupons up to 50%. However, added at 100 ppm concentration, Pectinex Smash® hindered dramatically the production of biofilm, since the weight of biofilm formed on the coupons was five times lower with 100 ppm of Pectinex Smash® than that without the enzyme. Therefore, the efficacy of using 100 ppm of this enzyme was comparable by using 1,000 ppm of the same enzyme.
Identification of main enzymatic component
Since Pectinex Smash® showed the best performance in the experiments described in the previous assays, more tests were carried out to further verify its effect against biofilm formed from the nonfiltrated water, containing fibers, fines and fillers that can affect the biofilm formation.
Pectinex Smash® is a product obtained from Aspergillus aculeatus that presents a wide range of enzymatic activities as various pectinolytic activities between them, a pectin methylestearase. To identify the active compound having the predominant role against biofilm, two related products, containing fractions of activities of Pectinex Smash® were also tested in the B10 L: Pectinex Ultra SP® (a mixture of mainly pectinolytic enzymes from A. aculeatus) and Novoshape® (a pectin methylesterase of A. aculeatus as main active enzyme). Figure 5 shows the effect achieved with those enzymatic products. Pectinex Ultra SP® had no effect on the formation of biofilm (Fig. 5), whereas the Pectinex Smash® treatment was effective to control biofilm formation as it shows the weight of dry biofilm on the coupons that was three times lower than that in the control experiment. Finally, the results obtained with Novoshape® showed that the dry weight of biofilm on the coupons was four times lower than that for the control experiment. Both Pectinex Smash® and Novoshape® preparations, include a pectin methylesterase. It can therefore be concluded that pectin methylesterase was the main enzyme or, at least one of the enzymes, responsible for the efficiency of Pectinex Smash® on the prevention and control biofilm.
Discussion
Results showed that out of the 19 products studied, the use of Pectinex Smash® and its fraction Novoshape® were the best way of preventing biofilm formation (having in common that they are both principally composed by the pectin methylestearase). Pectinex Smash® has a mixture of pectinolytic activities, and Novoshape ® is an enzymatic solution of a microbial pectin methylesterase (PME, E.C.3.1.1.11). The gene encoding the esterase enzyme is derived from fungus A. aculeatus and is transferred into a strain of the food-grade organism Aspergillus oryzae for commercial production. The NovoShape preparation has a declared activity of 10 PEU/mL and a temperature optimum of ~50°C (data provided by the manufacturer). This enzyme belongs to the carbohydrate esterase family, catalyses the hydrolysis of methyl ester groups and has high specificity for pectin substrates, a property widely used in food industry and in plant science (Suutarinen et al. 2002; Micheli 2001; Femenia et al. 1998).
Composition of biofilm polysaccharides is not fully known, but available data on planktonic EPS and a few biofilm EPS, suggest that some of their monomers are identical or similar to those in plant cell-wall materials (Sutherland 2005). In fact, some bacterial EPS have been reported to be substrates for enzyme mixtures from non-bacterial sources (Sutherland 2001).
Orgaz et al. 2006, in their case study on biofilm removal, concluded that on biofilm removal of Pseudomonas fluorescens, the enzyme pectin esterase produced by Trichoderma viride (which belongs to the same family as pectinese methylestearase), could possibly deacetylate a polysaccharide in the biofilm matrix, making it softer and possibly more porous (Orgaz et al. 2006, 2007). Many microbial EPS have different substituent groups as ketal-linked pyruvate or ester-linked acetyl groups. The removal of acyl groups, especially the acetate, can significantly affect the physical properties of polysaccharides. The removal of one of the substituents such as the acetyl group, in particular the acetate, influences the physical properties of EPS (Sutherland 1999).
Several fungi can degrade complex plant cell-wall material, by secreting a large variety of enzymes. This versatility makes commercial polysaccharide-degrading enzyme mixtures have a widespread use in multiple fields, such as fruit processing (McKay 1993) or wastewater treatment (Wesenberg et al. 2003). They could also be use to degrade bacterial biofilm matrices or prevent and control the formation of biofilm in the piping system of the paper mill waste water. Due to the EPS heterogeneity, a mixture of enzymes might be necessary for efficient biofilm degradation.
This research opens the way to provide a method of removing biofilms from surfaces submerged in water using an effective enzyme that could be combined with the use of a biocide. The use of an enzyme which is biodegradable and has a low toxicity is also environmentally acceptable and economically appealing because of its contribution to the minimisation of the use of biocides.
References
Bajpai P (1999) Application of enzymes in the pulp and paper industry. Biotechnol Prog 15:147–157
Bardouniotis E, Ceri H, Olson ME (2003) Biofilm formation and biocide susceptibility testing of Mycobacterium fortuitum and Mycobacterium marinum. Curr Microbiol 46:28–32
Blanco A (2003) Microbiology in papermaking. Recent Res Devel Appl Microbiol Biotechnol 1:187–134
Blanco A, Negro C, Gaspar I, Tijero J (1996) Slime problems in the paper and board industry. Appl Microbiol Biotechnol 46:203–208
Bott TR (1998) Techniques for reducing the amount of biocide necessary to counteract the effects of biofilm growth in cooling water systems. Appl Ther Engin 18:1059–1066
Burmolle M, Webb JS, Rao D, Hansen LH, Sorensen SJ, Kjelleberg S (2006) Enhanced biofilm formation and increased resistance to antimicrobial agents and bacterial invasion are caused by synergistic interactions in multi-species biofilms. Appl Microbiol Biotechnol 6:3916–3923
Carpentier B, Chassaing D (2004) Interactions in biofilms between Listeria monocytogenes and resident microorganisms from food industry premises. Int J Food Microbiol 97:111–122
Costerton JW (2007) The biofilm primer. Springer-Verlag Berlin, Heiderberg
Femenia A, Garosi P, Roberts K, Waldron KW, Selvendran RR (1998) Tissue-related changes in methyl-esterification of pectic polysaccharides in cauliflower (Brassica oleracea L. var. botrytis) stems. Planta 205:438–444
Jefferson K (2004) What drives bacteria to produce a biofilm? FEMS Microbiol Lett 236:163–173
Jensen A, Larsen M, Ingmer H, Vogel B, Gram L (2007) Sodium chloride enhances adherence and aggregation and strain variation influences invasiveness of Listeria monocytogenes strains. J Food Prot 70:592–599
Johnsrud SC (1997) Biotechnology for solving slime problems in the pulp and paper industry. Adv Biochem Eng Biot 57:311–328
Kielemoes J, Bultinck I, Storms H, Boon N, Verstraete W (2002) Occurrence of manganese-oxidizing microorganisms and manganese deposition during biofilm formation on stainless steel in brackish surface water. FEMS Microbiol Ecol 39:41–55
Kristensen JB, Meyer RL, Laursen BS, Shipovskov S, Besenbacher F, Poulsen CH (2008) Antifouling enzymes and the biochemistry of marine settlement. Biotechnol Adv 26:471–481
Lahtinen T, Kosone M, Tiirola M, Vuento M, Oker-Blom C (2006) Diversity bacteria contaminating paper machines. J Ind Microbiol Biotechnol 33:734–740
Longhi C, Scoarughi GL, Poggiali F, Cellini A, Carpentieri A, Seganti L, Pucci P, Amoresano A, Cocconcelli PS, Artini M, Costerton JW, Selan L (2008) Protease treatment affects both invasion ability and biofilm formation in Listeria monocytogenes. Microb Pathog 45:45–52
Mckay AM (1993) A review microbial carboxylic ester hydrolases (EC 3.1.1) in food biotechnology. Lett Appl Microbiol 16:1–6
Micheli F (2001) Pectin methylesterases: cell wall enzymes with important roles in plant physiology. Trends Plant Sci 6(9):414–419
N. N. Directive 98/8/EC of the European parliament and of the council of 16 February 1998 concerning the placing of biocidal products on the market
REACH Regulation (EC) No 1907/2006 of the European Parliament and of the Council of 18 December 2006 concerning the Registration, Evaluation, Authorisation and Restriction of Chemicals (REACH), establishing a European Chemicals Agency, amending Directive 1999/45/EC and repealing Council Regulation (EEC) No 793/93 and Commission Regulation (EC) No 1488/94 as well as Council Directive 76/769/EEC and Commission Directives 91/155/EEC, 93/67/EEC, 93/105/EC and 2000/21/EC
Orgaz B, Kives J, Pedregosa AM, Monistrol IF, Laborda F, SanJose C (2006) Bacterial biofilm removal using fungal enzymes. Enzyme Microb Technol 40:51–56
Orgaz B, Neufeld RJ, SanJose C (2007) Single-step biofilm removal with delayed release encapsulated Pronase mixed with soluble enzymes. Enzyme Microb Technol 40:1045–1051
Oulahal N, Martial-Gros A, Bonneau M, Blum LJ (2007) Removal of meat biofilms from surfaces by ultrasounds combined with enzymes and/or a chelating agent. Innovative Food Sci Emerg Technol 8:192–196
Pedersen K (1982) Method for studying microbial biopelículas in flowing-water systems. Appl Microbiol Biotechnol 46:6–13
Rättö M, Verhoef R, Suihko ML, Blanco A, Schols HA, Voragen AGJ, Wilting R, Siika-aho M, Buchert J (2006) Colanic acid is an exopolysaccharide common to many enterobacteria isolated from paper-machine slimes. J Ind Microbiol Biotechnol 33:359–367
Schenker AP, Gould IM (1996) Modern microbiological control in closed recycled paper systems. COST Action E1 Conference Improvement of recyclability and the recycling paper industry of the future. Las Palmas 24–26 November 155–162
Simoes M, Simoes L, Vieira M (2010) A review of current and emergent biofilm control strategies. Food Sci Technol 43:573–583
Sutherland I (1999) Polysaccharases for microbial exopolysaccharides. Carbohydr Polym 38:319–328
Sutherland IW (2001) Biofilm exopolysaccharides: a strong and sticky framework. Microbiol 147:3–9
Sutherland IW (2005) Microbial exopolysaccharides. In: Dumitriu S (ed) Polysaccharides, structural diversity and functional versatility. Marcel Dekker, New York, pp 431–457
Suutarinen J, Honkapää K, Heiniö R, Mustranta A, Liukkonen-lilja H, Mokkila M (2002) Modeling of calcium chloride and pectin methylesterase prefreezing treatments of strawberries and jams. J Food Sci 67(3):1240–1248
Torres CE, Gibello A, Nande M, Martin M, Blanco A (2008) Fluorescent in situ hybridization and flow cytometry as tools to evaluate the treatments for the control of slime-forming enterobacteria in paper mills. Appl Microbiol Biotechnol 8:889–897
Van Haute E (1999) Biodispersant and enzyme treatments. A new approach to deposit control. Proc. 53rd Appita Annual Conference, Rotorua, New Zealand 2575–579
Van Houdt R, Michielis C (2005) Role of bacterial cell surface structures in Escherichia coli biofilm formation. Res Microbiol 156:626–633
Verhoef R, Schols HA, Blanco A, Siika-aho M, Rattö M, Buchert J, Lenon G, Voragen AGJ (2005) Sugar composition and FT-IR analysis of exopolysaccharides products by microbial isolates from paper mill slime deposits. Biotechnol Bioeng 91:91–105
Wesenberg D, Kyriakides I, Agathos SN (2003) White-rot fungi and their enzymes for the treatment of industrial dye effluents. Biotechnol Adv 22:161–187
Acknowledgements
The authors wish to express their appreciation to European Union for supporting the Project “Eco-efficient Novel Enzymatic Concepts (GRDI-2000-25676)” and the Community of Madrid for funding the projects PROLIPAPEL I (S-0505/AMB-0100) and PROLIPAPEL II (S-2009/AMB-1480).
Author information
Authors and Affiliations
Corresponding author
Rights and permissions
About this article
Cite this article
Torres, C.E., Lenon, G., Craperi, D. et al. Enzymatic treatment for preventing biofilm formation in the paper industry. Appl Microbiol Biotechnol 92, 95–103 (2011). https://doi.org/10.1007/s00253-011-3305-4
Received:
Revised:
Accepted:
Published:
Issue Date:
DOI: https://doi.org/10.1007/s00253-011-3305-4